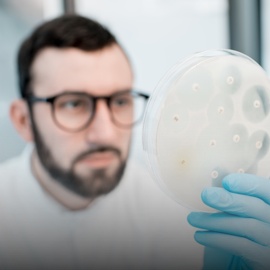

- /Home
- /About
- /PIPS
- /Apply
- /Current students
- /Supervisors
- /Partners
- /News
- /FAQs
- /Conference '25
- /Contact